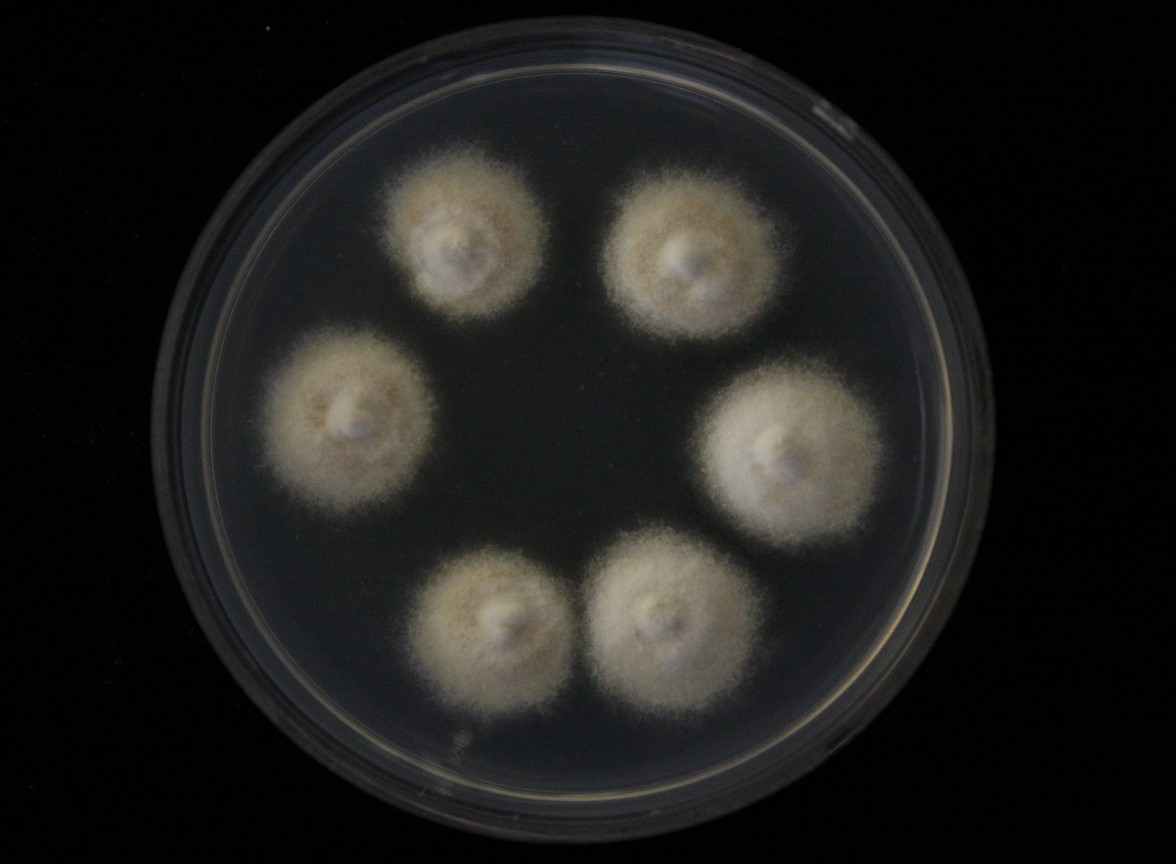

Holotype:
THAILAND, Phetchabun Province, Nam Nao National Park, 6 May 2009, K. Tasanathai, P. Srikitikulchai, S. Mongkolsamrit, T. Chohme, holotype BBH 27981, ex-type living culture BCC 36526.
Habitat:
Underside of a dicotyledonous leaf.
Host:
On Salticidae.
Description:
 Spider host covered by brown mycelial mat. Synnema arising directly from the host abdomen, erect, cylindrical, short stipe, white, 3 mm long, composed of parallel, densely compacted hyphae.
Spider host covered by brown mycelial mat. Synnema arising directly from the host abdomen, erect, cylindrical, short stipe, white, 3 mm long, composed of parallel, densely compacted hyphae.  Conidiophores hyaline, septate, 65–230 × 7–9 µm.
Conidiophores hyaline, septate, 65–230 × 7–9 µm.  Conidial heads, 37–44 µm diam. Vesicle ellipsoidal, subglobose to globose, smooth, hyaline, 9–12 × 7–10 µm. Metulae broadly ellipsoidal, hyaline, smooth occasionally, 7–10 × 6–7 µm. Conidia fusiform, in short chains, 4–5 × 2 µm. Conidiophores of Granulomanus synasexual morph present, well-differentiated, roughened to distinctly verrucose, particularly around the base. Phialides holoblastic, cylindrical, clavate, flask-shaped, to irregularly shaped, mostly verrucose, rarely smooth, with one to three conspicuous denticles, 8–13 × 3 µm, bearing solitary, long, filiform conidia. Conidia smooth, hyaline, 10–19 × 1–1.5 µm. Sexual morph present.
Conidial heads, 37–44 µm diam. Vesicle ellipsoidal, subglobose to globose, smooth, hyaline, 9–12 × 7–10 µm. Metulae broadly ellipsoidal, hyaline, smooth occasionally, 7–10 × 6–7 µm. Conidia fusiform, in short chains, 4–5 × 2 µm. Conidiophores of Granulomanus synasexual morph present, well-differentiated, roughened to distinctly verrucose, particularly around the base. Phialides holoblastic, cylindrical, clavate, flask-shaped, to irregularly shaped, mostly verrucose, rarely smooth, with one to three conspicuous denticles, 8–13 × 3 µm, bearing solitary, long, filiform conidia. Conidia smooth, hyaline, 10–19 × 1–1.5 µm. Sexual morph present.  Perithecia occurring on the mycelial mat covering the host body, superficial, ovoid, reddish-brown, twothird covered with the loose network of mycelia, 340–690 × 200–310 µm.
Perithecia occurring on the mycelial mat covering the host body, superficial, ovoid, reddish-brown, twothird covered with the loose network of mycelia, 340–690 × 200–310 µm.  Asci cylindrical, 340–530 × 7–10 µm. Asci caps, 4–5.5 × 5–8 µm.
Asci cylindrical, 340–530 × 7–10 µm. Asci caps, 4–5.5 × 5–8 µm.  Ascospores filiform, multiseptate, breaking into bacilliform part-spores, 3–9 × 1.5–2.5 µm.
Ascospores filiform, multiseptate, breaking into bacilliform part-spores, 3–9 × 1.5–2.5 µm.
Culture characteristics:
Colonies on PDA attaining a diam of 1.5 cm in 20 d at 25°C, white, velvety; reverse cream, becoming pale brown with age towards the centre.
Colonies on PDA attaining a diam of 1.5 cm in 20 d at 25°C, white, velvety; reverse cream, becoming pale brown with age towards the centre.
Reference:
Kuephadungphan W, Petcharad B, Tasanathai K, et al. (2022). Multi-locus phylogeny unmasks hidden species within the specialised spider-parasitic fungus, Gibellula (Hypocreales, Cordycipitaceae) in Thailand. Studies in Mycology101: 245–286.
DOI: https://doi.org/10.3114/sim.2022.101.04.Species |
Strain |
Compound |
Pubchem CID |
Biological activity |
Reference |
|---|
|
Strain |
ITS | LSU | RPB1 | RPB2 | TEF1 |
|---|---|---|---|---|---|
| BCC 36526 | OK040737 | - | OK040722 | OK040728 | OK040704 |
| BCC 36538 | MH532867 | MH394668 | MH521817 | MH521861 | MH521890 |